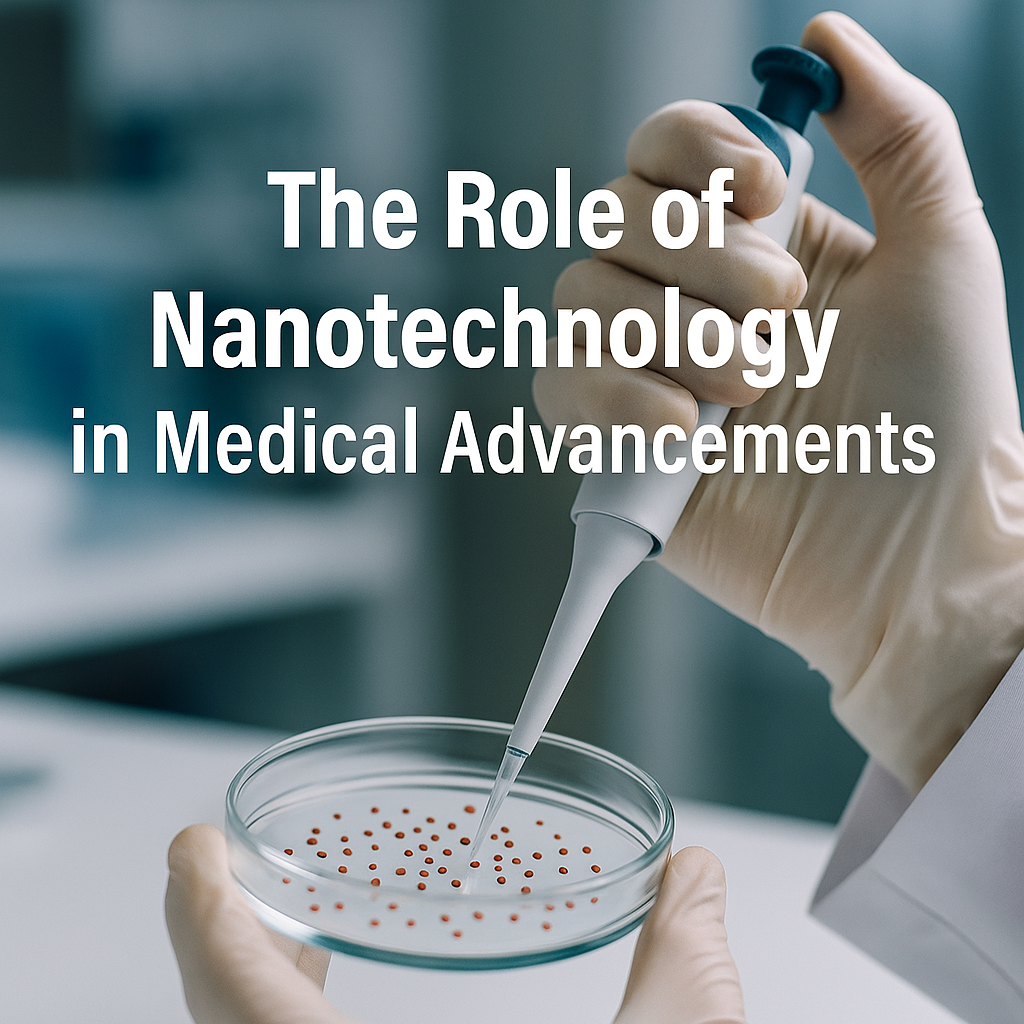
The Role of Nanotechnology in Medical Advancements

Latest News
Hiring Freelancers Overseas: Paying International Contractors Legally
In today’s global economy, entrepreneurs and small business owners increasingly tap into global talent. While hiring skilled professionals from various countries can be highly rewarding, it also presents challenges related to legal compliance and payment processing. Understanding how to engage international talent correctly is essential for smooth operations and maintaining a trustworthy reputation. Understanding the […]
Event Liability: Legal Considerations When Hosting Business Events
Hosting a business event—whether it’s a product launch, conference, or networking session—requires a perfect blend of creativity, logistics, and legal insight. Entrepreneurs and small business owners must address various legal considerations to ensure every detail runs flawlessly. From negotiating venue contracts to understanding guest liabilities, mastering event liability legal considerations is key to a successful […]
The Cost of Downtime: How Tech Outages Can Hurt Your Business
Imagine a busy Monday morning at your small business when suddenly your network goes down. Orders halt, staff are left idle, and productivity plummets. Regardless of your business size, an unexpected tech outage can disrupt operations, reduce team efficiency, and negatively affect your bottom line. In today’s digital world, downtime’s effect on business revenue is […]
Case Study: How One Company Used IoT to Streamline Operations
Small business owners and entrepreneurs are always seeking innovative strategies to stay ahead of the competition. In today’s fast-paced market, emerging technologies like IoT can be a true game changer. This case study details how a mid-sized company embraced IoT to optimize its operations, demonstrating a real-world example of streamlining efficiency through IoT integration. This […]
Self-Checkout Technology: Is It Right for Your Retail Business?
In today’s fast-paced retail world, entrepreneurs and small business owners are constantly seeking innovative ways to stay competitive. Self-checkout systems have emerged as a key solution, meeting the demand for faster, more efficient shopping experiences. By reducing wait times and freeing up staff for more personalized customer interactions, self-checkout technology offers a significant edge in […]
Quantum Computing: Breaking Barriers in Technology
Explore quantum computing breakthroughs that are revolutionizing small business innovation with transformative applications. ...
The Role of Nanotechnology in Medical Advancements
Experience advanced nanoparticle drug delivery for targeted therapies and faster diagnostics, transforming nanotechnology in medicine for better care. ...
3D Printing: Revolutionizing Manufacturing and Design
Transform your business with 3D printing manufacturing innovation—rapid prototyping, enhanced design flexibility, and sustainable production for a competitive edge. ...
The Rise of Autonomous Drones: Applications and Challenges
Discover how autonomous drones technology revolutionizes precision agriculture and emergency response with innovative, efficient solutions. ...